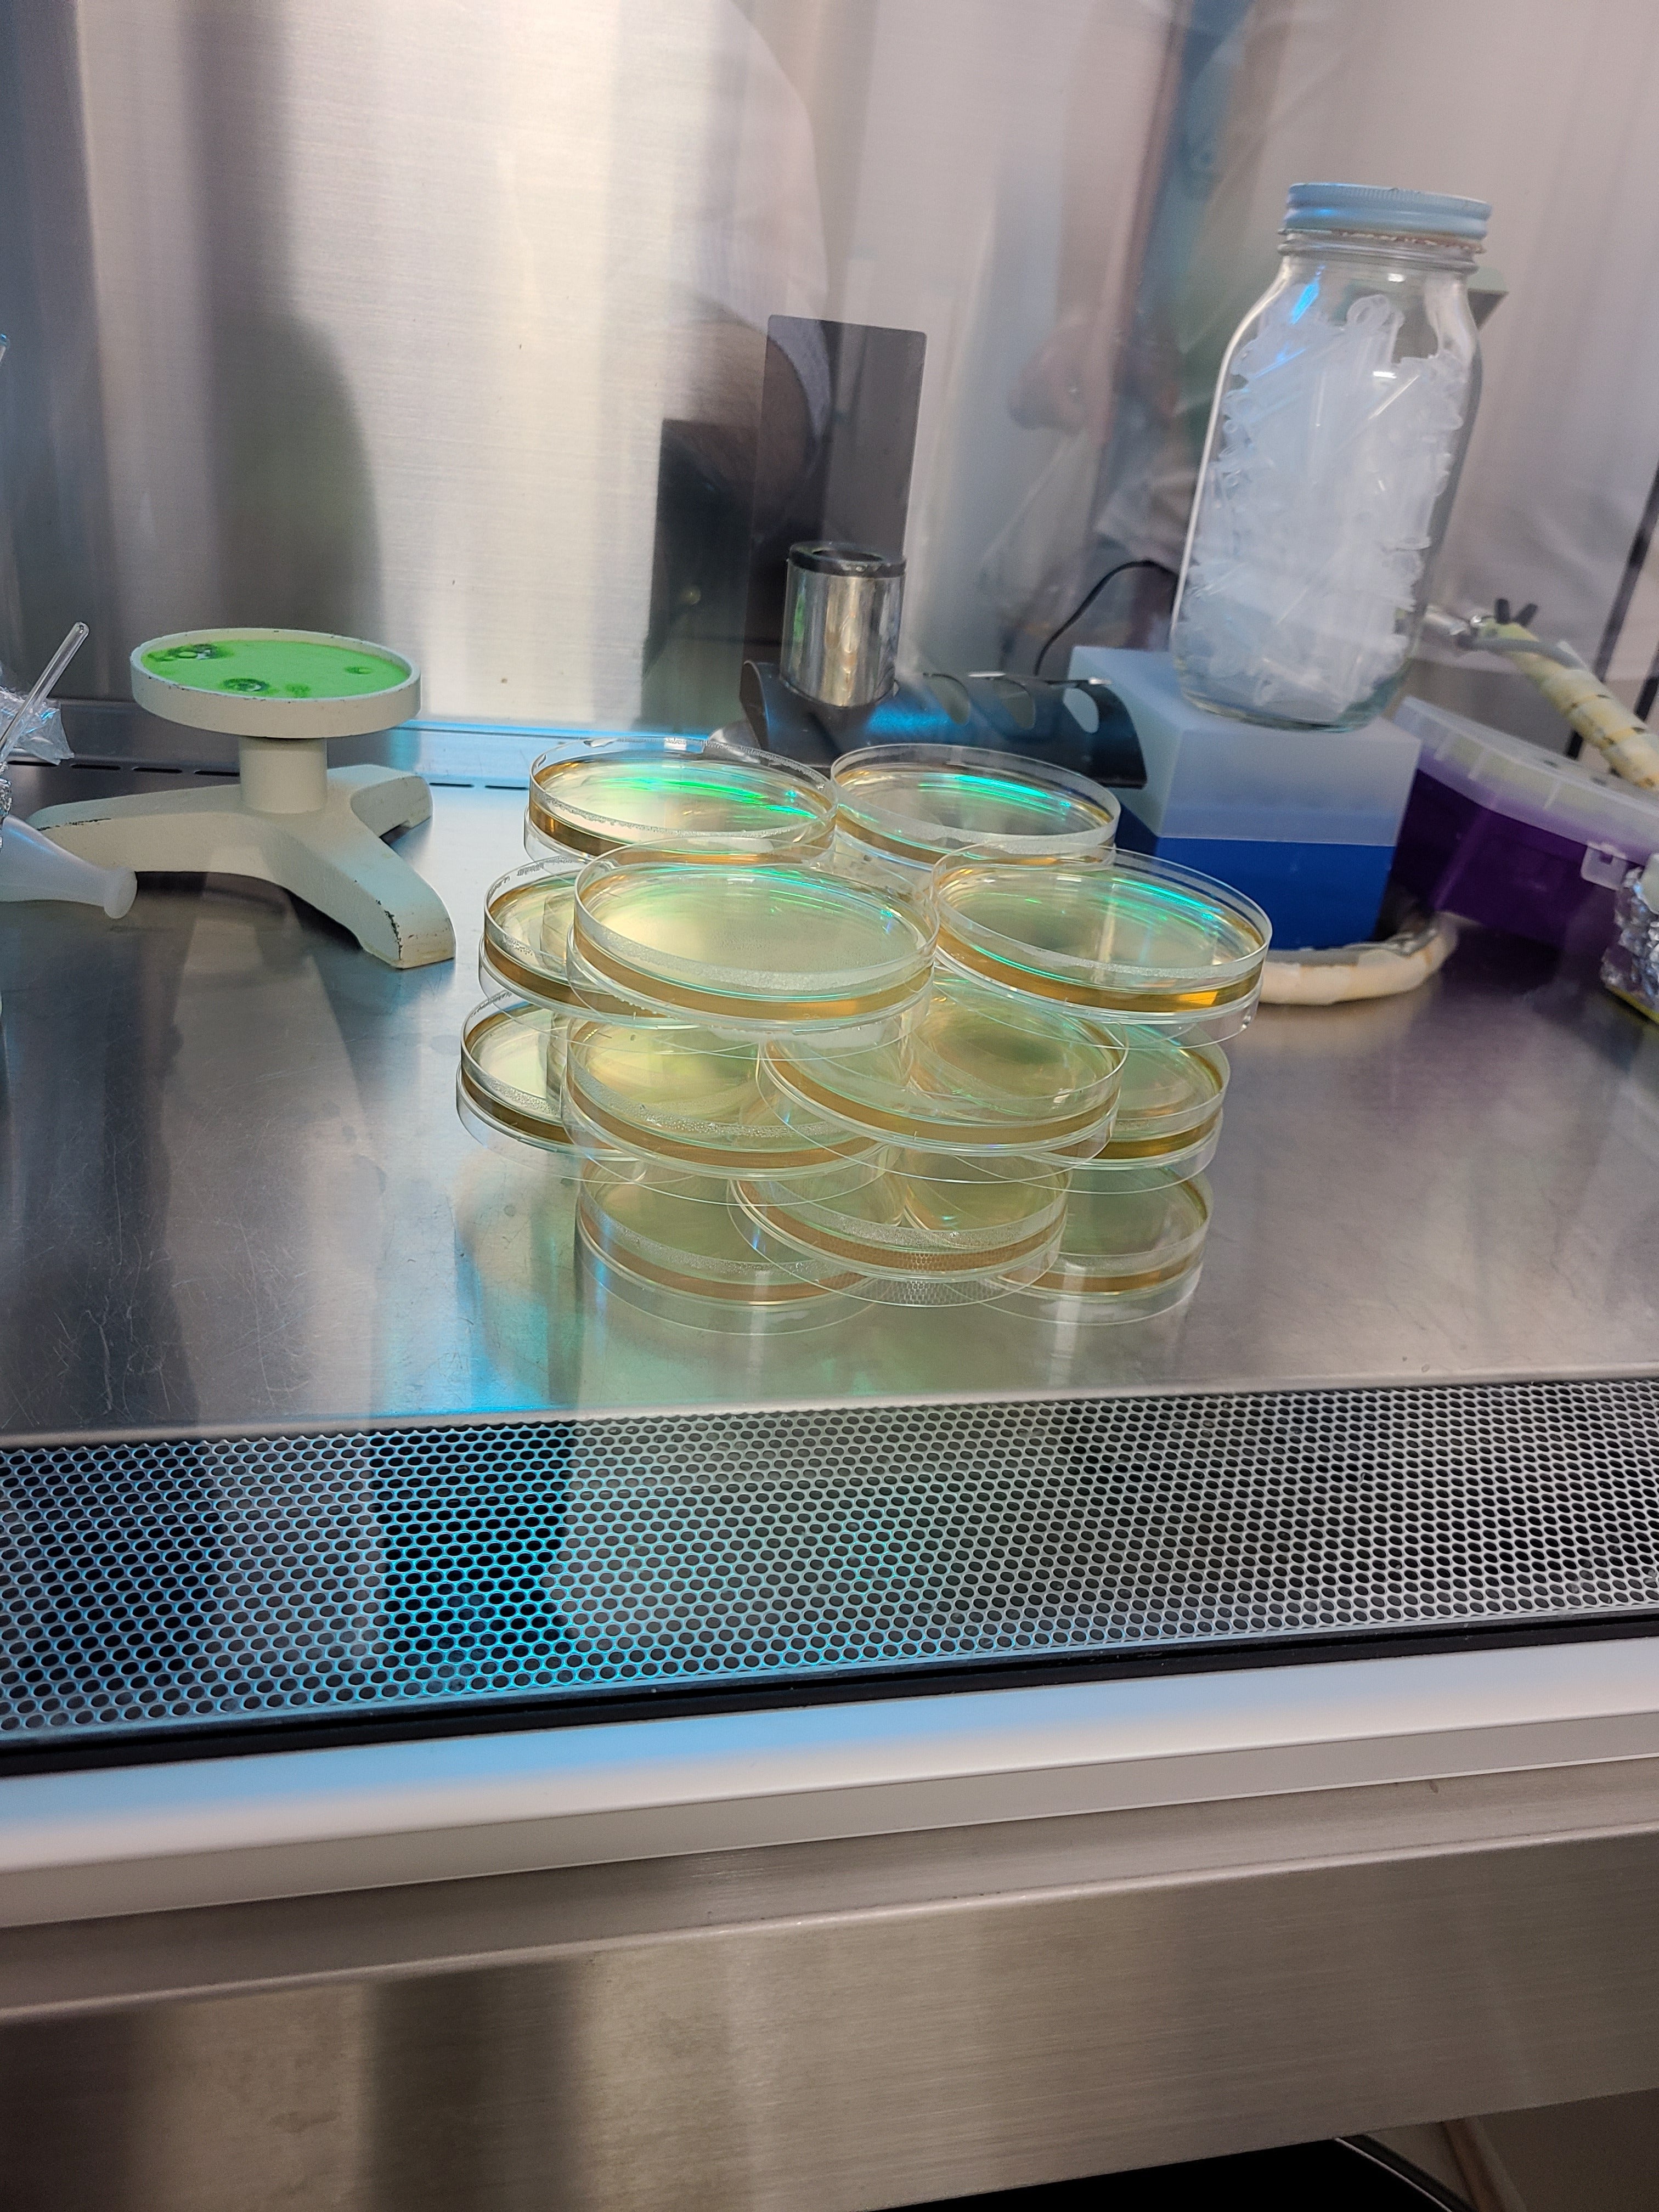

研究者として活動しています。新しい発酵技術で発酵生産性の向上を目指して研究しております。ご支援で実験設備(乳化機: ホモジナイザー他)を購入したいと思います。ご支援宜しくお願いいたします。
1目次
2はじめに
2-1研究のはじまり
2-2これまでの研究経緯
2-3今後の課題
2-4クラウドファンディングでの解決
2-5プロジェクトの理念
3おわりに
2はじめに
ダイナノファー乳化発酵研究所 の馬場です。多くのプロジェクトの中から本プロジェクトに来て頂き、本当にありがとうございました。
弊研究所は今年2月に設 立されました。まだ、出来て1ヶ 月です。名前の由来は、ギリシ ャ語 の力(ダイナ)と小さいと いう単位の一つ(ナノ)と英語の発酵のファーメンテーションの(フ ァー)を結びつけた造語で す。発酵に微粒子で力を、という願いを込めてダイナノファーと名 付けました。
わたしは最近まで、教育・研究機関で職員をしていました(2024年1月で定年退職しました)。そこでは乳化の研究が盛んで、わたしも乳化技術のサポートをしていました。わたしは微生物の培養を経験していたので、新たな領域として微生物に乳化を応用すべく乳化と発酵を結びつけました。
それが「エマルション発酵」です! 世界にまだない、始まったばかりの技術です!
このプロジェクトは、研究成果を皆様と共有し、多くの研究者が同じ方向を目指して研究を前に進めるためものです。「エマルション発酵」のための乳化液の試作を目的としております。そのため、ご支援を利用させて頂き、乳化設備を購入したいと思っています。目標95万円です。

わたしたちが病気にかかったときに、薬のお世話になります。例えば、手術では、点滴や注射で抗菌のための薬が使われます。とても身近なものです。この薬の重要な部分の原材料(ペニシリンやその誘導体)は、ほぼ100%中国から輸入しています。
一方、ペニシリン系の薬は、お子さんの薬としても重要です。溶連菌咽頭炎の場合、毎日3回、10日くらい使用することになります。また、幼児の急性中耳炎にも使用されることもあるそうです。幼児は、耳菅が短く水平に近いので、菌に感染するリスクが高いと聞きます。
このペニシリン系の薬が不足すると、セフェム系の薬が使われます。困ったことに、この薬は耐性菌の発生を増加させる危険性が指摘されています。このような薬不足の連鎖から、お子さんを始めとする大切な人を守る「仕組み」が欲しいと思いました。

日本では、この抗菌のための薬の原材料を安く作るための、発酵技術や設備が求められています。世界情勢をみると、病院で使用する薬の原材料を日本で作ることが出来た方が安心です。
2019年には、中国の工場の操業停止で、一部の原材料が入手できずに、日本では手術延期など少なからぬ影響がありました。
上記の薬の事例は、発酵という切り口での事例なのですが、よく考えてみると、わたしたちの身の回りでは、いろいろな化学品が発酵技術で作られています。
お酒、乳酸菌、アミノ酸、医薬品の原材料、味噌、醤油、洗剤の分解酵素などです。
今回のプロジェクトは、このようないろいろな化学薬品のために必要な、発酵全般の効率を向上させる技術です。それだけではなく、不十分な条件でも、菌体が安定的に有価物を生産してくれる可能性を持った技術です。
高度の機能を持っていない設備でも実現できる可能性があります。まずはアミノ酸の生産から検討を始めました。この方面ですと、応用の幅が広いと考えました。菌体が自分のまわりの栄養素などを取り込みやすくサポートする技術です。

上の写真で、左側の試験管が標準培地で、右側の試験管が乳化した培地です。この技術は始まったばかりの技術なので、いまのところ珍しい画像だと思っています。
これまで、アミノ酸発酵で発酵培地を乳化する発想をした人はいませんでした。過去から現在に至るまで、主として、微生物の遺伝子組み換えの取り組みや、微生物の代謝を改善するなどの、微生物の側に立った研究がされてきました。
一方、微生物を取り囲んでいる環境を改善する研究もされてきました。撹拌方法の改善、酸素吹き込み方法の改善、制御機能の改善、発酵熱の除熱方法の改善などでした。培地の組成を検討する取り組みも、かなり究極まできていると思います。
しかし、もっと大胆な、今回のプロジェクトのような培地を乳化する発想はありませんでした。

上の写真は、乳化処理で作った乳化液の顕微鏡観察写真です。円形の食用油の周辺に食品添加物の微粒子が存在します。食用油は、乳化液中できれいに分散しています。この乳化液を培地に対して5%の容量で加えます。
※一連の研究内容は、2024年3月25日の日本農芸化学会の年会で報告予定です。
2-1 研究のはじまり
このプロジェクトでは、研究成果を皆様と共有し、皆様とともに研究をさらに前に進めることを目的としております。ホモジナイザーなどの実験設備を、95万円のご支援で購入させてください。
研究を進めるうちに、壁にぶつかりました。 Corynebacterium glutamicumという菌で培養を開始しました。グルタミン酸を作る菌体で、古くて有名な菌です。この菌をベースにすれば、今回の狙いのアミノ酸生産に繋がります。
しかし、標準培地で、普通に培養してもグルタミン酸を作ってくれませんでした。これでは、培地を乳化するどころの話ではありません。
いったい何が悪いのか。調べるのに1年かかりました。

専門家の先生のところで勉強させて頂いたところ、どうやら、培養初期に効果を発揮する大豆系有効成分が適切に作用していないようなのです。また、振とうの仕方がとても弱いこともわかりました。
これが研究のスタートです。長いトライアルアンドエラーが始まりました。
しかし、驚いたことに、培地を乳化すると、菌体はグルタミン酸を作ってくれるようになりました。
菌体が置かれた環境が厳しいものであっても、菌体と培地の界面で乳化物が菌体をサポートするようなのです。詳しいことはわかりません。
わからないことだらけだからこそ、前に進みたい。これはまだ見ぬ未来の技術です。
太山の高きは一石に非ず(あらず)
卑しきを累ねて(かさねて)然る後に高し※
これはこのプロジェクトにふさわしい言葉だという気がしています。多くの方の協力で前に進めると思うのです。
※卑しきとは、もともと中国語なので日本語とニュアンスが少し異なります。取るにたらない、の意。「上の句」が有名ですが、「下の句」も好きです。
2-2これまでの研究経緯
食品添加物 と食用油だけを純水に投入して乳化処理で乳化液を作ります。通常、乳化する際に使用する界面活性剤は使用しません。製造した乳化液を、培地に容量で5%になるように投入して培地を乳化します。こうして「エマルション発酵」を始めます。
一連の操作を図にしてみたのが以下です。

この培地に菌体を投入して30℃、24時間、振とう培養した結果が次のグラフです。

培地を乳化したものは、ほとんどのものが、標準培地(乳化物が入っていない培地)よりもグルタミン酸の生成量が多いことがわかりました。標準培地中のグルタミン酸は、培地の薬剤由来で、菌体はグルタミン酸を作っていません。
菌体の細胞膜を機械的に破壊して、菌体内部に保留しているグルタミン酸を測定しましたが、菌体内部にはグルタミン酸はありませんでした。
🔘標準培地がダメだった理由?
標準培地でグルタミン酸を作らなかった理由が、初期の大豆系有効成分が機能しないためなのかもしれません。これは初期段階の発酵で菌体にとって、とても重要な栄養素です。
上記の大豆系有効成分は、大豆を酸加水分解した試薬を購入し、適量を計算してそのまま水に溶解して投入しました。専門の発酵メーカーは大豆を酸と高温で処理して有効成分を投入しています。
あるいは、振とうの程度が小さいためなのかもしれません。この方面の研究者は、専用の特殊フラスコを用い、大型振とう機で激しく振とうします。私の振とう機は、メスフラスコがせいぜいで、少ししか振とうしません。

そう考えると、生育に厳しい環境条件であったかもしれません。
わたしの方法と設備では、100回以上培養して、1度もグルタミン酸を作りませんでした。
しかし、培地を乳化したものはすぐにグルタミン酸を生成しました。前に記載したことの繰り返しになりますが、不十分な条件での発酵を、乳化がサポートしているようにみえたのです。
🔘技術ポイント
食品添加物は、乳化によく使用するものです。一連の研究の結果、食品添加物の主鎖の長さが大事だとわかりました。長さが中程度、あるいは、長い方が良いようです。側鎖の種類と個数も大事です。個数は2個でも効果的ですが1個が最適です。どうも食品添加物の立体構造に鍵があるようなのです。
適正な濃度もわかりました。2%でした。それ以上、増加させても発酵成績は変わりません。
それぞれの食品添加物の濃度に調整した乳化液を示したのが、次の写真です。食品添加物のほかに、それぞれ10%濃度になるように食用油が入っています。
食品添加物の濃度として、左から、0.5%、1%、2%、3%、5%、7%です。
この2%の乳化液(写真では左から3番目)を、培地の量に対して5%容量で培地に入れるのです。すなわち、950ミリリットルの培地に、写真の左から3番目の乳化液を、50ミリリットル入れます。
発酵に使用することを念頭に置いたこのような乳化液はいまのところまだ世の中にはないのではないかと思っています。

乳化のための必要試薬は、培地に対して、微量(1Lの培地で6g程度: 食品添加物1g 、食用油5g など)で済むわけです。これは工業的にはとても重要なポイントであると考えております。乳化のための薬剤費が安価で済むということです。
さらに、この濃度を狙って5倍の濃度で作って、水で5倍希釈もできるのです。今回の乳化処理で可能なわけですが、従来の方法での乳化液は、このように希釈することはできません。
希釈できることは、今回の技術の特徴のひとつで、生産現場で、大きな威力を発揮すると思います。製造するにしても輸送するにしても、労力は低減するはずです。
一方、振とう培養ではなく、空気を直接吹き込むジャー培養でも培養をやってみました。傾向は振とう培養と変わりませんでした。実験状況の写真を示します。

向かって右側が乳化した培地です。左側が通常の標準培地です。泡の立ち方が明確に違います。乳化した培地はほとんど泡が発生しませんでした。現場的には、発酵の際に消泡剤を入れる必要がなくなるかもしれません。泡立たないということは、発酵の場合はとても大事なことだと思うのです。
実験室レベルでも、左側の培地は、泡が上から、あるいは、容器の接合部からどんどん出てきてしまい2回に1回はやり直ししました。実際の発酵槽レベルでも、泡が発生すると厄介なことになるでしょう。
<別の菌ではどうか?>
●乳酸菌
Corynebacterium glutamicumだけではなく、乳酸菌でも効果を発揮しました(効率はcoryneよりも落ちます)。最適な食品添加物はCorynebacterium glutamicumの場合と同じです。
●酵母
Corynebacterium glutamicumだけではなく、酵母でも効果を発揮しました(効率はcoryneよりも落ちます)。最適な食品添加物はCorynebacterium glutamicumと少し立体構造が異なりましたが、同じ種類の食品添加物でした。
今回、乳化物が微生物の有用物質生産に良い影響を与えました。「エマルション発酵」は有益かもしれません。しかし、まだ、メカニズムの解明が進んでいません。
現時点で得られたデータから考察すると、 菌体の周囲に存在する乳化物は、菌体に近接・接触しながら、必要とする大豆系有効成分をはじめとした栄養素の取り込みや、空気の取り込みをサポートする役割だったかもしれません。Corynebacterium glutamicumに比べて乳酸菌や酵母で効率が落ちるのは、「空気の取り込みがあるかないか」の違いかもしれません。


一方、十分な条件にある菌体には、効果を発揮しないのかもしれません。
ここからは、微生物の代謝に関して高度な研究をされているいろいろな研究者の方の領域であると考えています。バトンタッチしながら、この「エマルション発酵」の理屈を解明していきたいと思います。
好気性のCorxnebacterium glutamicumにも、嫌気性の乳酸菌と酵母にも、どの菌体にも有効であったということは、「エマルション発酵」の技術としての幅を考えると、重要であると考えます。
🔘「エマルション発酵」が創る未来
「エマルション発酵」でアミノ酸の生産がより容易になるかもしれません。アミノ酸発酵は、幅広く産業に利用でき、今回の技術は、アミノ酸に限らず多くの分野で威力を発揮するかもしれません。
例えば、冒頭で少し触れたペニシリンの話に繋がります。この技術はペニシリンなどを作る菌にも応用できる可能性があります。
(讀賣新聞2023年11月10日掲載の記事を参考にして作りました)
抗菌作用のあるペニシリンは医療現場ではかかせません。細菌感染症の治療に活用されるだけではなく、手術後の合併症を防ぐためにも必要です。ペニシリンを使えなければ、患者を重症化させかねない現状があります。
でも、わたしたちはペニシリンの原材料を中国での生産に依存しています。わたしたちが日常的に当たり前に手に入ると思っている物資は、コストの壁によって、中国に依存せざる負えないのです。コストをおさえて日本で発酵できる環境が必要です。
一方、そのような緊迫した現場から一般のフィールドに目を移してみると、酵母や乳酸菌は世界中の多くの現場で利用されています。発酵技術に新たな革新技術が導入されれば、きっと今以上に、世界の多くの人が発酵製品を手にできるようになるでしょう。バイオエタノールも安く作れるようになるかもしれません。
発酵産業のコストを下げる取り組みは、とても大事な方向性を持っているのです。

図は、菌体の周囲に存在する乳化物が、菌体に近接・接触しながら、必要とする大豆系有効成分をはじめとした栄養素や空気を取り込んでいるイメージ図です。
その他にもまだまだ、適用可能な菌体や分野が大きく広がる予感があります。メタン発酵や他の菌なども可能かもしれません。世界がより良く変わる可能性に思いをはせると、心が明るくなります。
2-3 今後の課題
これからの展開です。Corynebacterium glutamicumと乳酸菌と酵母に関して、それぞれ、有効な乳化物がわかりました。キーポイントは、食品添加物(これはどれも同じ種類)の濃度と立体構造です。これは対象とする菌体によって異なるようです。
ただ、残念なことに、私は定年退職してしまい、身近に乳化を行うための装置がありません。
そこで、今回、クラウドファンディングで、乳化のための装置を購入させて頂き、設立した研究所で試作品を作る体制を作りたいと思っております。
多くの方にご賛同頂けると幸いです。
2-4クラウドファンディングでの解決
目標
今回購入する装置は以下です。乳化だけの設備に限定すると、この1/2程度の費用です(わたしは実験設備を消耗品から全て揃えるので、この費用となります)
<概要>
・設備費65万円
・クラウドファンデイング手数料(17%+税)
・消費税(10%)
<設備詳細>
・ホモジナイザー、ローター購入
・殺菌装置購入
・吸光光度計購入
・消耗品設備購入
合計95万円
2-5プロジェクトの理念
クラウドファンディングには、様々な形式が存在し、それぞれの考え方や事情があると思います。今回のプロジェクトは実験・検証系のものです。こちらのクラウドファンディングでは、あまり事例は多くないかもしれません。
それだけに、多くの方に賛同いただいて、ひとつの目標を共有したいと考えます。その結果、技術に触れてみたい多くの方に、技術資料やweb会議などでの情報入手機会を、ご負担の少ない形で、広く提供したいと思います。今回のプロジェクトの理念です。多くの方にご賛同頂けると幸いです。
3おわりに
ダイナノファー乳化発酵研究所 の馬場です。今回、このプロジェクトにご興味を持っていただき本当にありがとうございます。
これまで、教育・研究機関の職員として、通常業務の傍ら、一連の研究をして参りました。いくつか有望な配合を見いだしました。これから、というタイミングでしたが、残念なことに、2024年1月で私は定年退職になってしまいました。
定年退職は仕方ありません。しかし、進め方がもう少し上手だったら、もう少しこの発酵技術を広げる方法があったかもしれません。「発酵」と「乳化」という2つの境界領域の研究なので、限られた時間の中で、多くのことができませんでした。
多くの方に認めてもらうには、理論的な面が弱かったと反省しています。もっと、学問を深める横の繋がりや仲間を作るべきでした。

そのようなわけで、定年退職とともにこの研究は終わることになりました。もう実験する場所はありません。実験器具もありません。でも、あきらめ切れませんでした。まだ、出来ることがあるのではないか? もしかしたら、この技術は社会に少しでも貢献できたのではないか?
そこで、自宅の一室に研究所を作り、研究を継続することを思い立ちました。せめて、技術資料やサンプルを広く配布しよう。そのための環境を整えることを検討しております。新しい発酵技術の開発で、一緒に世界を変えませんか?
応援のほどをよろしくお願いいたします。
ダイナノファー乳化発酵研究所
所長 馬場文雄
・博士(経営学 : 横浜国立大学)
専門は ナレッジマネジメント
・博士(工学 : 北海道大学)
専門は 微生物による金属の腐食(MIC: Microbially Induced Corrosion)
・MBA(横浜国立大学)
専門は 効果的な小集団活動のため
のビジネススキル
経歴
1985年、食品・発酵会社に入社、2018年、早期退職。以降、教育・研究機関 教員、職員を経て、2024年1月定年退職。退職と同時に ダイナノファー乳化発酵研究所 設立、現在に至る。

リターンについて
🔳1,000円
●簡単な活動報告書
(基本的な活動報告書)
🔳2,500円
●活動報告書
(学会発表内容を含む活動報告書)
🔳4,000円
●大規模web説明会へのご招待
●開催時間:40分程度
・10月5日(土)11時から40分
・10月26日(土)11時から40分
どちらも限定500名
🔳6,000円
●個別web会議へのご招待
●開催時間:1時間程度
限定30名
🔳15,000円
●技術を説明するyoutube動画(20分程度)配信
🔳30,000円
●出張説明会
●開催時間:1時間半程度
旅費(実費:交通費と宿泊費)は別途ご相談
限定30名
🔳50,000円
●出張説明会
旅費(実費:交通費と宿泊費)は別途ご相談
●開催時間:1時間半程度
●youtube配信の動画とは別の動画CDをお持ちします
●活動報告書に、お名前あるいは企業様名を記載させて頂きます(希望される方)
限定30名
🔳その他、特別な返礼品が不要な方に向けたコースが設定されています。お気持ちありがとうございます。大切に使わせて頂きます。
<募集方式について>
本プロジェクトはAll-or-Nothing方式で実施します。目標金額に満たない場合、計画の実行及びリターンのお届けはございません。
最新の活動報告
もっと見るご支援ありがとうございました
2024/04/26 07:05沢山のご支援ありがとうございました。残念ながら、目標額には届きませんでしたが、多くの方から暖かい励ましを頂きました。本当にありがとうございました。今回は及びませんでしたが、これからも研究を続けて参ります。秋には生物工学会の学会があるので、そちらも頑張りたいと思います。皆様の暖かいご支援を力に変えてこれからも進めて参ります。引き続きどうぞ宜しくお願いいたします。 もっと見る
残り10時間を切りました
2024/04/25 14:22残り10時間を切りました。最後まで頑張りたいと思います。ご支援、宜しくお願いいたします。 もっと見る残り14時間です。
2024/04/25 09:43このプロジェクトも残すところ14時間となりました。ご支援を宜しくお願いいたします。 もっと見る




コメント
もっと見る